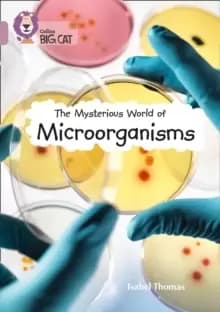
The Mysterious World of Microorganisms : Band 18/Pearl

The Mysterious Mr. Davis / The Lad Prices Comparison
Best price offer of £4.45 from verified retailer along with 1 top marketplace related listings.
Our website uses affiliate links. We may earn a commission for qualifying purchases. Learn More

The Mysterious Mr. Davis / The Lad
Listed at
MusicMagpie
Price
£4.45Product Details & Information
Marketplace Related Listings
1 Listing
Compare Trusted Stores Prices
1 offer
Related Products on Amazon
Browse similar listings from Amazon sellers offering competitive prices and buying choices.
Related DVDs Movies & Shows Products
Compare similar products related to The Mysterious Mr. Davis / The Lad to explore alternative options.
Popular DVDs Categories
Compare popular DVDs categories to find the best products and deals
Explore More DVDs Products
Browse and compare other popular DVDs products to find the right option for you.
Shop & Compare Prices for The Mysterious Mr. Davis / The Lad
Compare prices for the The Mysterious Mr. Davis / The Lad across retailers to understand availability and buying options.
Comparing prices for the The Mysterious Mr. Davis / The Lad can help shoppers understand how pricing and availability vary across retailers. As part of the wider Movies & Shows category, this DVDs product may be offered by different retailers in new, used or refurbished conditions, with prices changing over time. Shopping Price Comparison helps you compare prices for the The Mysterious Mr. Davis / The Lad from trusted retailers and marketplaces in one place. Viewing multiple listings side by side makes it easier to see current market pricing, assess retailer options and understand differences between available offers. This comparison-led approach helps shoppers make informed decisions, avoid unnecessary overspending and choose an option that suits their needs and budget.
Price Compare
Compare prices from multiple trusted retailers.
Market View
See current pricing across different retailers.
Retailer Options
Review offers from various verified stores.
Confident Choice
Make informed buying decisions easily.

You May Also Like
Discover more product options & choices on shopping price comparison
Popular Movies & Shows Brands
Compare Movies & Shows products from well known brands available across retailers.
Compare Popular Movies & Shows
Discover popular Movies & Shows and compare prices from trusted sellers to find the right deal.

Comparing The Mysterious Mr. Davis / The Lad Prices with Confidence
Understand pricing differences and buying options for The Mysterious Mr. Davis / The Lad before choosing the deal that suits you best.
When comparing prices for The Mysterious Mr. Davis / The Lad, it’s helpful to look beyond individual listings and understand how pricing can vary across the wider market. Differences in price may reflect factors such as product condition, retailer pricing strategies, stock availability or additional services like delivery and returns. By reviewing multiple offers together, shoppers can build a clearer picture of how The Mysterious Mr. Davis / The Lad is positioned at any given time. This approach supports more confident decision-making, helping you recognise fair value and avoid relying on a single price point when assessing available options.
Comparing prices with confidence also means understanding what matters most to you as a buyer. Some shoppers prioritise lower upfront cost, while others may value retailer reputation, warranty coverage or convenience. Price comparison allows you to weigh these considerations side by side rather than focusing solely on headline pricing. By
Confident Comparison
Compare prices for The Mysterious Mr. Davis / The Lad across sellers to understand value, availability and buying options clearly.
Clear Market View
See how The Mysterious Mr. Davis / The Lad prices vary across the market to assess fair value confidently.
Smarter Decisions
Use price comparison insights for The Mysterious Mr. Davis / The Lad to choose offers matching your budget and preferences.

The Mysterious Mr. Davis / The Lad FAQs
Helpful answers about pricing, availability and comparing The Mysterious Mr. Davis / The Lad across retailers and marketplaces.






![The Mysterious Mr Davis / The Lad [DVD]](https://m.media-amazon.com/images/I/51S5mlJw-GL._SL500_.jpg)

 Similar Choice
Similar Choice![Poor Things [DVD] DVD - Comedy](/_next/image?url=https%3A%2F%2Fcdn.shoppingpricecomparison.com%2Fassets%2Fpublic%2Fimages%2Fproducts%2F10%2F88%2F1088aaf1-beda-46fe-8442-1da30517a8fb.webp&w=640&q=75)
![What Happens Later? [DVD] DVD - Comedy](/_next/image?url=https%3A%2F%2Fcdn.shoppingpricecomparison.com%2Fassets%2Fpublic%2Fimages%2Fproducts%2Fdd%2Feb%2Fddeb3002-dee2-4e49-8145-8192268710b0.webp&w=640&q=75)
![Rumble Through the Dark [DVD] DVD - Action Adventure](/_next/image?url=https%3A%2F%2Fcdn.shoppingpricecomparison.com%2Fassets%2Fpublic%2Fimages%2Fproducts%2F0b%2F31%2F0b31d59f-0dd3-43db-8479-d07b6c70da87.webp&w=640&q=75)
![Dead Shot [DVD] DVD - Drama](/_next/image?url=https%3A%2F%2Fcdn.shoppingpricecomparison.com%2Fassets%2Fpublic%2Fimages%2Fproducts%2Ff8%2F8b%2Ff88ba9a5-39f3-41e1-93b0-9f47f6f03cee.webp&w=640&q=75)
![The Shift [DVD] DVD - Science Fiction](/_next/image?url=https%3A%2F%2Fcdn.shoppingpricecomparison.com%2Fassets%2Fpublic%2Fimages%2Fproducts%2F5d%2Fea%2F5dea125f-8c65-4a11-a32d-b12acb0f70cc.webp&w=640&q=75)
![Silent Witness: Series 27 [DVD] DVD - Drama](/_next/image?url=https%3A%2F%2Fcdn.shoppingpricecomparison.com%2Fassets%2Fpublic%2Fimages%2Fproducts%2F7c%2Ffa%2F7cfaa4fe-d06a-4d87-be44-18fcb7563005.webp&w=640&q=75)
![The Portable Door [DVD] DVD - Action Adventure](/_next/image?url=https%3A%2F%2Fcdn.shoppingpricecomparison.com%2Fassets%2Fpublic%2Fimages%2Fproducts%2F0e%2F91%2F0e917fb2-a823-478a-acd9-a45a6c46cfa8.webp&w=640&q=75)
![Aquaman and the Lost Kingdom [DVD][2023] DVD - Action Adventure](/_next/image?url=https%3A%2F%2Fcdn.shoppingpricecomparison.com%2Fassets%2Fpublic%2Fimages%2Fproducts%2Fb9%2F8c%2Fb98cdbcf-82f3-42a0-a40f-31163220050a.webp&w=640&q=75)
![Shetland Series 8 [DVD] DVD - Drama](/_next/image?url=https%3A%2F%2Fcdn.shoppingpricecomparison.com%2Fassets%2Fpublic%2Fimages%2Fproducts%2Ffc%2F89%2Ffc8982a1-146a-4dec-a8bc-6a6ba23a8b7c.webp&w=640&q=75)
![Thanksgiving [DVD] DVD - Horror](/_next/image?url=https%3A%2F%2Fcdn.shoppingpricecomparison.com%2Fassets%2Fpublic%2Fimages%2Fproducts%2F28%2F6a%2F286a9357-539b-47ce-a846-1820c962c3fd.webp&w=640&q=75)
![Fireheart [DVD]](/_next/image?url=https%3A%2F%2Fcdn.shoppingpricecomparison.com%2Fassets%2Fpublic%2Fimages%2Fproducts%2F9c%2Fed%2F9cedebfa-4ba6-4f03-8ad4-f9aa4e28c12f.webp&w=640&q=75)
![GI Joe Snake Eyes [DVD] [2021]](/_next/image?url=https%3A%2F%2Fcdn.shoppingpricecomparison.com%2Fassets%2Fpublic%2Fimages%2Fproducts%2Fc9%2F70%2Fc970d7ee-adca-4635-a528-468c9ff8603d.webp&w=640&q=75)
![Star Wars Original Trilogy Box Set DVD (Episodes 4-6) [2022]](/_next/image?url=https%3A%2F%2Fcdn.shoppingpricecomparison.com%2Fassets%2Fpublic%2Fimages%2Fproducts%2F64%2F94%2F64942c92-6d9b-412a-b9ee-55ab3574a8e5.webp&w=640&q=75)
![Werewolf Santa [DVD]](/_next/image?url=https%3A%2F%2Fcdn.shoppingpricecomparison.com%2Fassets%2Fpublic%2Fimages%2Fproducts%2Fdf%2F01%2Fdf01c29f-7866-49f0-b421-67c523769f31.webp&w=640&q=75)


![Star Trek: Prodigy - Season 1 [DVD]](/_next/image?url=https%3A%2F%2Fcdn.shoppingpricecomparison.com%2Fassets%2Fpublic%2Fimages%2Fproducts%2F24%2F7f%2F247f10da-f423-4ddb-b196-decc7dbbd76a.webp&w=640&q=75)


![The Flash [DVD] [2023]](/_next/image?url=https%3A%2F%2Fcdn.shoppingpricecomparison.com%2Fassets%2Fpublic%2Fimages%2Fproducts%2F0b%2F5c%2F0b5c9903-53c4-4ed7-9e83-7177c4572741.webp&w=640&q=75)

![Nightmare Alley DVD [2022]](/_next/image?url=https%3A%2F%2Fcdn.shoppingpricecomparison.com%2Fassets%2Fpublic%2Fimages%2Fproducts%2F87%2F85%2F87857a90-d9fe-4cc1-8863-005f8626d5d9.webp&w=640&q=75)
![The Boat Story [DVD]](/_next/image?url=https%3A%2F%2Fcdn.shoppingpricecomparison.com%2Fassets%2Fpublic%2Fimages%2Fproducts%2F35%2F96%2F359627ec-3793-4333-aef6-94e3302ee85a.webp&w=640&q=75)
![The Super Mario Bros. Movie [DVD] [2023]](/_next/image?url=https%3A%2F%2Fcdn.shoppingpricecomparison.com%2Fassets%2Fpublic%2Fimages%2Fproducts%2F8f%2F53%2F8f537a22-cb46-4563-a77c-54d6a6934dc4.webp&w=640&q=75)

![Time: Series 2 [DVD]](/_next/image?url=https%3A%2F%2Fcdn.shoppingpricecomparison.com%2Fassets%2Fpublic%2Fimages%2Fproducts%2F63%2F49%2F6349f451-ce25-41f1-a1bf-042315b73566.webp&w=640&q=75)
![The Lair [DVD]](/_next/image?url=https%3A%2F%2Fcdn.shoppingpricecomparison.com%2Fassets%2Fpublic%2Fimages%2Fproducts%2Fc3%2F98%2Fc3986571-df1f-4ea4-afd5-3abb73d61d19.webp&w=640&q=75)
![NCIS: The Twentieth Season [DVD]](/_next/image?url=https%3A%2F%2Fcdn.shoppingpricecomparison.com%2Fassets%2Fpublic%2Fimages%2Fproducts%2Fe1%2F9a%2Fe19a165a-7c87-4e16-981b-c15ed7a9377f.webp&w=640&q=75)
![Saw X [DVD]](/_next/image?url=https%3A%2F%2Fcdn.shoppingpricecomparison.com%2Fassets%2Fpublic%2Fimages%2Fproducts%2F81%2F8d%2F818dba1b-59b0-413e-8508-0a68aba7afff.webp&w=640&q=75)
![The Old Oak [DVD]](/_next/image?url=https%3A%2F%2Fcdn.shoppingpricecomparison.com%2Fassets%2Fpublic%2Fimages%2Fproducts%2Fa7%2F62%2Fa762af07-8930-4409-b906-8c192961fdd2.webp&w=640&q=75)
![Past Lives [DVD]](/_next/image?url=https%3A%2F%2Fcdn.shoppingpricecomparison.com%2Fassets%2Fpublic%2Fimages%2Fproducts%2F87%2F5c%2F875cba25-9e0d-4c6f-8195-e77e7c642e68.webp&w=640&q=75)



![Wes Anderson Boxset [DVD]](/_next/image?url=https%3A%2F%2Fcdn.shoppingpricecomparison.com%2Fassets%2Fpublic%2Fimages%2Fproducts%2F8c%2F11%2F8c116f69-b4aa-4efe-b8d7-a929f44a2f5c.webp&w=640&q=75)
![A Haunting In Venice [DVD]](/_next/image?url=https%3A%2F%2Fcdn.shoppingpricecomparison.com%2Fassets%2Fpublic%2Fimages%2Fproducts%2F63%2Fd9%2F63d991aa-77ef-4906-b7c7-69cc1caa2271.webp&w=640&q=75)















![Disney Pixar's Inside Out 2 [DVD] TVFILM - DVD](/_next/image?url=https%3A%2F%2Fcdn.shoppingpricecomparison.com%2Fassets%2Fpublic%2Fimages%2Fproducts%2F01%2Fd9%2F01d9f737-44c4-4d56-80af-58bd2122600a.webp&w=640&q=75)

![Anyone But You [DVD] TVFILM - DVD](/_next/image?url=https%3A%2F%2Fcdn.shoppingpricecomparison.com%2Fassets%2Fpublic%2Fimages%2Fproducts%2Fa1%2F85%2Fa185a023-8c46-476e-bbf4-7fdaf16886f6.webp&w=640&q=75)
![Spider-Man: Across the Spider-verse/Into the Spider-verse [DVD] TVFILM - DVD](/_next/image?url=https%3A%2F%2Fcdn.shoppingpricecomparison.com%2Fassets%2Fpublic%2Fimages%2Fproducts%2F1e%2Fd5%2F1ed56142-7c7e-43fb-94b6-dd634a612ab1.webp&w=640&q=75)





![The Blackening [DVD] TVFILM - DVD](/_next/image?url=https%3A%2F%2Fcdn.shoppingpricecomparison.com%2Fassets%2Fpublic%2Fimages%2Fproducts%2F9a%2Fa6%2F9aa6c26b-fa8f-463a-9122-b36e5c2a0f8c.webp&w=640&q=75)
![Fun Boy Three - The Complete Fun Boy Three [CD / Box Set with DVD] Music CDs - Music CD](/_next/image?url=https%3A%2F%2Fcdn.shoppingpricecomparison.com%2Fassets%2Fpublic%2Fimages%2Fproducts%2F1a%2F21%2F1a21ef76-46d0-4f3d-826d-44e9ed656317.webp&w=640&q=75)


![The Walking Dead: Daryl Dixon Season 1 [DVD] TVFILM - DVD](/_next/image?url=https%3A%2F%2Fcdn.shoppingpricecomparison.com%2Fassets%2Fpublic%2Fimages%2Fproducts%2F2e%2Ffd%2F2efd8c51-39d5-4ab7-9970-3f5fece5f390.webp&w=640&q=75)
![A New Breed of Criminal [DVD] TVFILM - DVD](/_next/image?url=https%3A%2F%2Fcdn.shoppingpricecomparison.com%2Fassets%2Fpublic%2Fimages%2Fproducts%2F63%2Fc6%2F63c6e943-3f7d-4653-9374-3ad7ab7f3f64.webp&w=640&q=75)

![BTS - BTS, the BEST [CD / Box Set with DVD] Music CDs - Music CD](/_next/image?url=%2F_next%2Fstatic%2Fmedia%2Fno-product-image.1655-nkebogy0.webp&w=640&q=75)


![John Zorn - The Hermetic Organ, Vol. 9 [CD / Album with DVD] Music CDs - Music CD](/_next/image?url=https%3A%2F%2Fcdn.shoppingpricecomparison.com%2Fassets%2Fpublic%2Fimages%2Fproducts%2F8f%2Fad%2F8faddcf9-f1c0-44c4-995b-d6fb6b91714b.webp&w=640&q=75)
![Robert Fripp - Washington Square Church [CD / Album with DVD] Music CDs - Music CD](/_next/image?url=https%3A%2F%2Fcdn.shoppingpricecomparison.com%2Fassets%2Fpublic%2Fimages%2Fproducts%2F09%2Fc8%2F09c87194-2e57-4176-8915-8cbb61ac283a.webp&w=640&q=75)









![Toomorrow [DVD] TVFILM - DVD](/_next/image?url=https%3A%2F%2Fcdn.shoppingpricecomparison.com%2Fassets%2Fpublic%2Fimages%2Fproducts%2F90%2F67%2F90670e33-5e3a-4719-920c-7f20397f9ec6.webp&w=640&q=75)



![The Fall Guy [DVD] TVFILM - DVD](/_next/image?url=https%3A%2F%2Fcdn.shoppingpricecomparison.com%2Fassets%2Fpublic%2Fimages%2Fproducts%2F80%2F2f%2F802f8e45-f6b1-48c9-9480-8d1463c6e3b1.webp&w=640&q=75)





![Billy Connolly: Big Banana Feet [Bluray] Bluray - Bluray - Documentary](/_next/image?url=https%3A%2F%2Fcdn.shoppingpricecomparison.com%2Fassets%2Fpublic%2Fimages%2Fproducts%2Fda%2Fbc%2Fdabc94f7-efb3-490f-bf25-4292d95be83b.webp&w=640&q=75)





![Killer Nun (Limited Edition) [Bluray] Bluray - Bluray - Horror](/_next/image?url=https%3A%2F%2Fcdn.shoppingpricecomparison.com%2Fassets%2Fpublic%2Fimages%2Fproducts%2Fff%2F34%2Fff34b2ff-e9e4-4724-8f94-93e3b02037a5.webp&w=640&q=75)



![Big Time Gambling Boss [Bluray] Bluray - Arthouse & World Cinema](/_next/image?url=https%3A%2F%2Fcdn.shoppingpricecomparison.com%2Fassets%2Fpublic%2Fimages%2Fproducts%2Fb5%2F74%2Fb574e94e-bfdb-4ca6-b701-a64e5f76dc4a.webp&w=640&q=75)









![A Perfect Planet [DVD] [2021] DVD - Documentary](/_next/image?url=https%3A%2F%2Fcdn.shoppingpricecomparison.com%2Fassets%2Fpublic%2Fimages%2Fproducts%2F1e%2F32%2F1e3282bb-81fe-400a-a54c-18bb73669d00.webp&w=640&q=75)

![Little Women (2019) [Bluray] Bluray - Bluray - Drama](/_next/image?url=https%3A%2F%2Fcdn.shoppingpricecomparison.com%2Fassets%2Fpublic%2Fimages%2Fproducts%2Fad%2F9a%2Fad9aa3b8-783f-4768-bcc7-59f20a4ed7d7.webp&w=640&q=75)
![Butcher, Baker, Nightmare Maker [Bluray] Bluray - Bluray - Horror](/_next/image?url=https%3A%2F%2Fcdn.shoppingpricecomparison.com%2Fassets%2Fpublic%2Fimages%2Fproducts%2F75%2F02%2F7502a245-a384-485e-aaf5-cc1fb68d0703.webp&w=640&q=75)